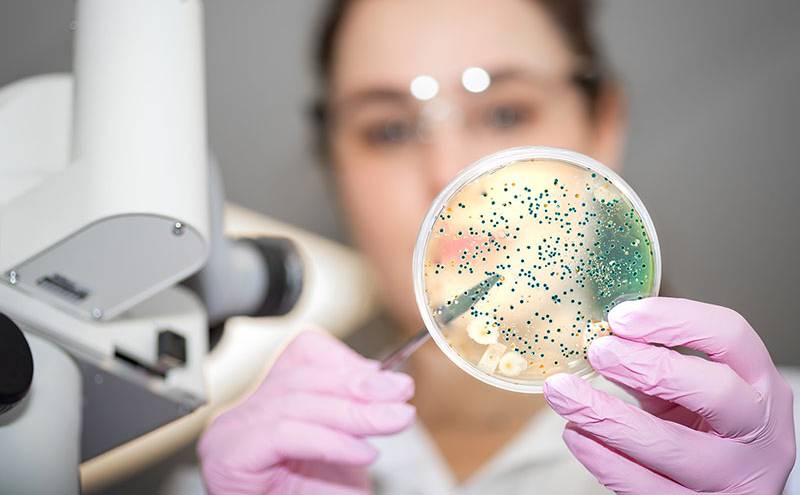
Các phương pháp xét nghiệm bệnh lậu phổ biến có độ chính xác cao

Bệnh lậu là gì? Nguyên nhân, dấu hiệu, chẩn đoán, cách chữa
- 3 tuyệt chiêu giúp mẹ bảo vệ con khi thời tiết thay đổi thất thường
- Các biểu hiện của viêm đường hô hấp ở trẻ dễ gây nhầm lẫn
- Bệnh tim mạch là gì? Nguyên nhân, chẩn đoán và cách điều trị
- Bệnh phổi tắc nghẽn mãn tính kiêng ăn gì và nên ăn gì?
Bệnh lậu là một trong những bệnh lây qua đường tình dục thường gặp do lậu cầu khuẩn gây ra. Lậu cầu được Neisser tìm ra năm 1879 trong mủ ở bộ phận sinh dục của bệnh nhân bị bệnh lậu. Ngoài ảnh hưởng đến hoạt động sinh hoạt hàng ngày nó còn để lại hậu quả vô sinh nếu không được phát hiện và điều trị kịp thời.
1. Tìm hiểu định nghĩa bệnh lậu là gì?
Giới thiệu về bệnh lậu là gì?
Bệnh lậu là bệnh nhiễm khuẩn bằng đường sinh dục, đường da, niêm mạc… do lậu cầu khuẩn (Neisseria gonorrhoeae). Lậu cầu khuẩn này chỉ tìm thấy ở người mà không tìm thấy trong thiên nhiên.
Nguyên nhân gây ra bệnh lậu ở nam và nữ: Do vi khuẩn lậu cầu (Neisseria gonorrhoeae) gây ra. Lậu cầu khuẩn là vi khuẩn hiếu khí tuyệt đối (là vi khuẩn tồn tại,phát triển trong môi trường có oxy), nó có hình hạt cà phê xếp thành từng đôi và hai mặt dẹt quay vào nhau. Lậu cầu khuẩn không có vỏ, không có nhân, không sinh nha bào (bào tử).
Theo nghiên cứu từ các tổ chức y tế: Lậu cầu khuẩn gây bệnh lậu ở người có sức đề kháng rất kém, sau ra khỏi cơ thể của người bệnh chúng chết rất nhanh. Lậu cầu khuẩn dễ bị tiêu diệt ở nhiệt độ khoảng 58°C trong vòng khoảng một giờ. Một số các chất sát khuẩn thông thường như axit phenix 1%, formol 0,1% có khả năng giết chết lậu cầu khuẩn trong khoảng từ 2 đến 5 phút.
- Thời gian ủ bệnh: bình thường bệnh lậu ủ bệnh trong thời gian ngắn khoảng 2-7 ngày.

Một số hình ảnh minh họa bệnh lậu ở nữ và nam
2. Dấu hiệu bệnh lậu ở nam giới và nữ giới
Triệu chứng và dấu hiệu bệnh lậu như thế nào còn tùy vào từng trường hợp nhiềm bệnh. Theo ghi nhận tại các cơ sở y tế khoảng 10-20% bệnh lậu ở nữ và rất ít trường hợp nhiễm bệnh lậu ở nam giới không có triệu chứng. Có khoảng 25% trường hợp nam giới nhiễm bệnh có các triệu chứng tối thiểu.
2.1. Triệu chứng của bệnh lậu ở nam
-Chảy mủ từ trong niệu đạo (là đoạn cuối của đường dẫn nước tiểu đi từ bàng quang ra ngoài), chảy nhiều, màu xanh hay màu vàng đặc.
- Một vài trường hợp kèm hoặc không các dấu hiệu: tiểu nhiều, tiểu rắt, tiểu ra mủ và có cảm giác đau dọc niệu đạo khi đi tiểu.
- Khi dương vật cương cứng và khi quan hệ tình dục đau, xuất tinh đau buốt có khi kèm theo máu.
- Nếu như viêm toàn bộ niệu đạo có các triệu chứng sau: mệt mỏi, đái khó kèm theo sốt, đái dắt…
- Triệu chứng khi bệnh lậu đã bị biến chứng nặng : viêm tuyến tiền liệt, viêm ống dẫn tinh, viêm túi tinh, viêm mào tinh ( thường bị một bên với các dấu hiệu của quá trình viêm sưng, nóng, đỏ, đau kèm theo sốt hoặc hai bên gây mất khả năng sinh dục).

Biểu hiện bệnh lậu ở nam giới dễ phát hiện sau thời gian ủ bệnh
2.2. Triệu chứng nhận biết của bệnh lậu ở nữ:
Ở một số trường hợp dấu hiệu bệnh lậu ở phụ nữ thường diễn ra âm thầm thậm chí còn không có dấu hiệu nhận biết nên nhiều chị em không để ý mình đã bị bệnh và lây lan cho mọi người.
- Các triệu chứng bệnh lậu cấp tính ở phụ nữ:
+ Niệu đạo: chảy mủ; dịch trắng đục, màu xanh hoặc vàng đặc; có mùi hôi. Khi khám niệu đạo có dấu hiệu đỏ.
+ Cổ tử cung: chảy máu ở ống cổ tử cung. Khi khám thấy cổ tử cung phù nề, đỏ, chạm vào chảy máu.
+ Ngoài ra chị em sẽ thấy triệu chứng đau bụng dưới, đau khi quan hệ tình dục.
=>> Vi khuẩn Neisseria gonorrhoeae cũng là nguyên nhân gây viêm niệu đạo và những bộ phận khác nhau của đường sinh dục như viêm mào tinh hoàn, viêm tuyến tiền liệt, viêm vòi trứng, viêm cổ tử cung. Ngoài ra lậu cầu khuẩn còn có thể biến chứng gây viêm khớp, viêm màng trong tim, viêm khuẩn huyết, viêm kết mạc ở trẻ sơ sinh khi qua đường sinh dục ở người mẹ bị bệnh lậu.

Triệu chứng và biểu hiện của bệnh lậu ở nữ giới dễ phát hiện
3. Bệnh lậu lây qua đường nào?
Bệnh lậu lây truyền trực tiếp từ người sang người chủ yếu bằng đường sinh dục. Đặc biệt có nguy cơ cao ở những đối tượng quan hệ tình dục không an toàn (âm đạo, miệng, hậu môn..)
Một con đường truyền nhiễm khác đó là qua đường da, niêm mạc, kết mạc, giác mạc khi sử dụng chung đồ dùng sinh hoạt với người bệnh như: bồn tắm, bồn cầu, khăn tắm, khăn mặt..
4. Các phương pháp xét nghiệm bệnh lậu phổ biến hiện nay
Bệnh phẩm để xét nghiệm bệnh lậu:
-Ở đàn ông: lấy mủ niệu đạo vào sáng sớm trước khi đi tiểu thứ nhất trong ngày.
- Ở phụ nữ: lấy mủ ở lỗ niệu đạo, cổ tử cung, các lỗ của tuyến âm đạo.
4.1. Phương pháp làm tiêu bản nhuộm Gram soi kính hiển vi
- Hình thể và tính chất bắt màu của lậu cầu khuẩn:
+ Trên tiêu bản nhuộm Gram, lậu cầu khuẩn có hình hạt cà phê xếp thành từng đôi, hai mặt dẹt quay vào nhau, bắt màu Gram âm. Nếu nhuộm xanh methylen thì bắt màu xanh.
Trong trường hợp người bệnh mắc bệnh lậu cấp tính thì vi khuẩn nằm trong tế bào bạch cầu đa nhân.
Trong trường hợp người bệnh mắc bệnh lậu mãn tính thì trên tiêu bản soi được ít thấy vi khuẩn, thường thấy vi khuẩn nằm ở ngoài tế bào.
+ Lậu cầu khuẩn không có vỏ, không có lông, không sinh nha bào (bào tử)
- Cách chẩn đoán bệnh lậu: Bệnh phẩm được nhuộm Gram hoặc nhuộm xanh methylen, soi dưới kính hiển vi thấy rất nhiều bạch cầu đa nhân.,
+ Trong đó có một số bạch cầu chứa đầy song cầu Gram âm hình hạt cà phê không lẫn với một loại vi khuẩn nào khác thì có thể chẩn đoán xác định bệnh lậu cấp tính.
+ Trường hợp bị bệnh lậu mãn tính thì trên tiêu bản ít thấy vi khuẩn và vi khuẩn nằm ngoài tế bào, có thể có nhiều loài khuẩn khác nhau, việc chuẩn đoán trở nên khó khăn do đó cần phải sử dụng phương pháp nuôi cấy phân lập để xác định.
+ Một số trường hợp nếu không lấy được mủ, có thể lấy nước tiểu ly tâm rồi lấy cặn nhuộm soi và nuôi cấy nhưng thường ít có kết quả.
Các phương pháp xét nghiệm bệnh lậu phổ biến có độ chính xác cao
4.2. Phương pháp nuôi cấy phân lập vi khuẩn
-Tính chất nuôi cấy của lậu cầu khuẩn:
+Lậu cầu khuẩn là vi khuẩn hiếu khí tuyệt đối, rất khó phát triển trên môi trường nuôi cấy thông thường mà nó đòi hỏi môi trường nuôi cấy phải có chứa nhiều chất dinh dưỡng như ở môi trường máu huyết thanh hoặc điều kiện môi trường có chứa 10% khí CO2.
Để phát hiện và chẩn đoán bệnh Lậu, bác sĩ chuyên khoa thường sử dụng môi trường Thayer-Martin để nuôi cấy.
+ Trên môi trường đặc, ở nhiệt độ 37°C, sau khoảng 48 giờ lậu cầu khuẩn phát triển tạo thành các khuẩn lạc nhỏ, tròn, dẹt, màu xanh nhạt.
- Chuẩn đoán bệnh lậu bằng phương pháp nuôi cấy lậu cầu khuẩn: Bệnh phẩm được lấy vào môi trường Thayer- Martin để tủ ấm 37°C với môi trường chứa 10% khí CO2. Sau khoảng 48 giờ xem hình thái của khuẩn đó, tiến hành nhuộm soi lại nếu như thấy song cầu Gram âm thì làm các phản ứng sinh vật hoá học để xác định lậu cầu khuẩn.
4.3. Phương pháp chẩn đoán gián tiếp:
Trong một số biểu hiện bệnh, nhất là viêm khớp do lậu cầu khuẩn khi dùng phương pháp nuôi cấy phân lập vi khuẩn thường vẫn cho kết quả âm tính, lúc này bác sĩ chuyên khoa có thể yêu cầu làm thêm phản ứng huyết thanh để chẩn đoán. Phương pháp thường dùng là phản ứng kết hợp bổ thể (kháng nguyên cộng kháng thể) với kháng nguyên là vi khuẩn lậu đã ly giải. Phản ứng này có tính đặc hiệu và có giá trị trong chẩn đoán xác định lậu cầu khuẩn.
4.4. Cách phân biệt lậu cầu khuẩn và não mô cầu:
Não mô cầu có hình thể rất giống lậu cầu. Trong đó các song cầu Gram âm hai mặt lõm quay mặt vào nhau giống hình hạt cà phê. Phương pháp để phân biệt 2 loại này là dựa vào tính chất không lên men đường: Lậu cầu khuẩn không lên men đường maltose, sacarose, levulose. Não mô cầu không lên men đường lactose, sacarose.
| Gây bệnh | Vi khuẩn | Glucose | Maltose | Levulose |
| Đường sinh dục | Lậu cầu khuẩn | Dương tính | Âm tính | Âm tính |
| Đường hô hấp | Não mô cầu | Dương tính | Dương tính | Âm tính |
5. Cách chữa bệnh lậu dựa theo phác đồ điều trị của bác sĩ:
- Nguyên tắc điều trị: Cách chữa bệnh lậu bằng kháng sinh Penicillin vẫn còn tác dụng tốt đối với lậu cầu khuẩn. Tuy nhiên hiện nay lậu cầu khuẩn đề kháng với Penicillin cho nên việc điều trị trở nên khó khăn hơn rất nhiều nhất là bệnh lậu mãn tính. Vì thế tốt nhất là chúng tôi tiến hành điều trị theo kháng sinh đồ.
- Các loại thuốc chữa bệnh lậu thường được bác sĩ chỉ định:
Hiện nay ứng dụng nền y học trên thế giới và cả y học Việt Nam Bác sĩ chuyên ngành phụ sản luôn luôn nhấn mạnh việc sử dụng kháng sinh Ceftriaxone (thuộc nhóm kháng sinh cephalosporin) để điều trị bệnh lậu với các trường hợp nhiễm liên cầu khuẩn ở bất cứ một vị trí nào trên cơ thể. Ngoài ra kết hợp dùng kháng sinh Azithromycin hoặc dùng doxycyclin để điều trị triệt để và làm giảm nguy cơ tạo ra những vi khuẩn kháng sinh nhóm cephalosporin.
Trong tất cả các vùng trên cơ thể thì nhiễm liên cầu khuẩn ở vùng hầu là khó điều trị hơn cả nên khi bị nhiễm ở những vùng này nên dùng kháng sinh Ceftriaxone. Phác đồ điều trị bệnh lậu bằng thuốc:
+ Tiêm bắp Cefotaxim 1g/ liều duy nhất.
+ Tiêm bắp Spectinomycin 2 gam/ liều duy nhất. Dùng để chữa nhiễm liên cầu khuẩn vùng trực tràng, sinh dục.
+ Tiêm bắp Ceftriaxone 250 mg /liều duy nhất.
+ Uống Cefixim 400mg / liều duy nhất.
• Nếu bệnh nhân dị ứng với kháng sinh nhóm Penicillin thì chống chỉ định dùng nhóm kháng sinh cephalosporin.
• Nếu dùng kháng sinh Azithromycin cần đề phòng lậu cầu khuẩn tạo ra chủng kháng kháng sinh nhóm Macrolides.

Thuốc tiêm điều trị bệnh lậu thường được bác sĩ phụ khoa và nam khoa chỉ định
6. Nguyên tắc phòng chống bệnh lậu theo khuyến cáo từ cục y tế dự phòng
- Nguyên tắc phòng chống bệnh lậu:
+ Vacxin phòng bệnh ít có kết quả. Chủ yếu là phát hiện sớm và điều trị triệt để cho bệnh nhân.
+ Bên cạnh đó cần phải làm tốt công tác giải quyết các vấn đề tệ nạn xã hội, tuyên truyền giáo dục các biện pháp phòng bệnh hoa liễu trong quan hệ nam nữ.
* Lưu ý trong sinh hoạt tránh lây nhiễm bệnh lậu:
+ Sử dụng dụng cụ vệ sinh riêng, sạch sẽ: khăn tắm,chậu rửa, xà phòng tắm…
+ Quan hệ tình dục một cách lành mạnh, an toàn.
+ Không nên quan hệ tình dục không có trách nhiệm, thủy chung với vợ hoặc chồng của mình.
+ Khi đã phát hiện ra mình bị bệnh không nên e ngại hãy liên hệ với chúng tôi để được điều trị kịp thời tránh gây ra những hậu quả đáng tiếc sau này.
* Nguyên tắc khi điều trị bệnh Lậu với cán bộ y tế:
+Hiểu biết đây là một trong số những bệnh nhạy cảm không phải bệnh nhân nào cũng có đủ can đảm đến khám vì vậy cần bảo mật về thông tin cá nhân, tư vấn và điều trị kịp thời.
+ Bệnh nhân mắc bệnh lậu là những đối tượng không cần phải cách ly.
+ Những chị em làm nghề mại dâm, người nghiện ma túy ngoài việc điều trị thì cần được giáo dục về kiến thức, thực hành…

Nguyên tắc phòng bệnh tránh lâu nhiễm vi khuẩn lậu cầu
Trên đây là các thông tin về bệnh lậu, một trong những căn bệnh STD gây lây nhiễm khi quan hệ tình dục. Các trường hợp mắc bệnh không nên giấu diếm hoặc tự điều trị bệnh lậu tại nhà tránh để bệnh biến chứng khó kiểm soát.

































